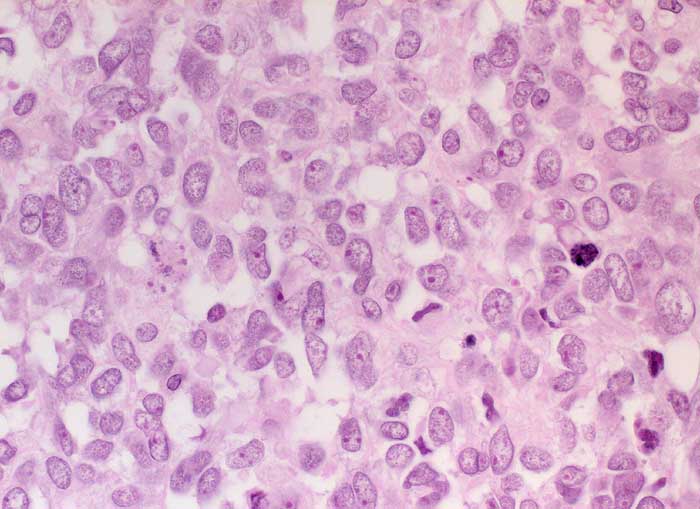

PathoPic – image database / PathoPic ID 6290 - Adenosarkom
de
Diagnose
Adenosarkom
Diagnose Gruppe
maligner Tumor
Topographie
Uterus
Topographie Gruppe
Genitalorgane, weiblich
Beschreibung
In diesem Bildausschnitt ist ausschliesslich der Anteil des Stromasarkoms erfasst. Die Stromazellen sind hochgradig atypisch und polymorph. Vermehrt Mitosen.
Klinik
Postmenopausale Blutungsstörung, sonographisch suspekter Endometriumbefund, klinisch V.a. Endometriumkarzinom.
Bilder Typ
Histologie
Vergrösserung
400
Alter
84
Geschlecht
unbekannt
Datum
Ersteintrag: 31.01.2003
Update: 10.08.2010